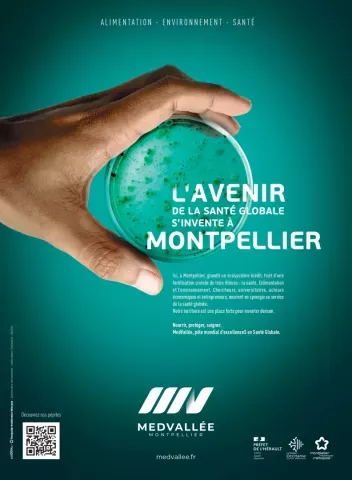
santé-globale-montpellier

MedVallée : l'avenir s'invente ici
30/04/2024
Auteur
Cette actualité est proposée par Bon et Local BOCAL
MedVallée, c'est un projet de territoire avec une ambition et des moyens. Faire de Montpellier un pôle mondial d'excellence en santé globale en fédérant dans la même dynamique les acteurs des filières alimentation, environnement et santé. Faites connaissance avec cet écosystème inédit qui grandit sur le territoire.
Avec MedVallée, tous les acteurs économiques, académiques et de la recherche, au croisement des trois filières d'excellence (Alimentation - Environnement - Santé ) du territoire métropolitain se fédèrent au sein d'une communauté puissante et visible. Dynamique économique, attractivité de la recherche, puissance académique sont les terreaux fertiles qui alimentent la stratégie MedVallée, créatrice de valeur ajoutée et d'emplois pour le bassin de vie de Montpellier.
Alimentation
Siège du pôle de recherche mondial Agropolis International, Montpellier accueille une des plus grandes communautés scientifiques en agriculture, alimentation, biodiversité et environnement au monde. Avec 2 700 chercheurs et enseignants et la présence du 1er pôle de compétitivité agricole et alimentaire français : Agri Sud-Ouest Innovation, la Métropole est le centre d’un écosystème favorisant l’innovation par la synergie entre la recherche et les entreprises. Une quarantaine d'entreprises agro-techs (représentant environ 900 emplois) sont en activité sur le territoire : Smag (groupe InVivo), ITK, Fruition Sciences, Matahi, Il était un Fruit, Qualiplante, ADNid, Envilys, Nyseos, Indatech, Histalim...
La Métropole de Montpellier déploie une politique agroécologique et alimentaire collaborative exemplaire (la P2A).
Découvrez la suite de l'article sur le site encommun.montpellier.fr
